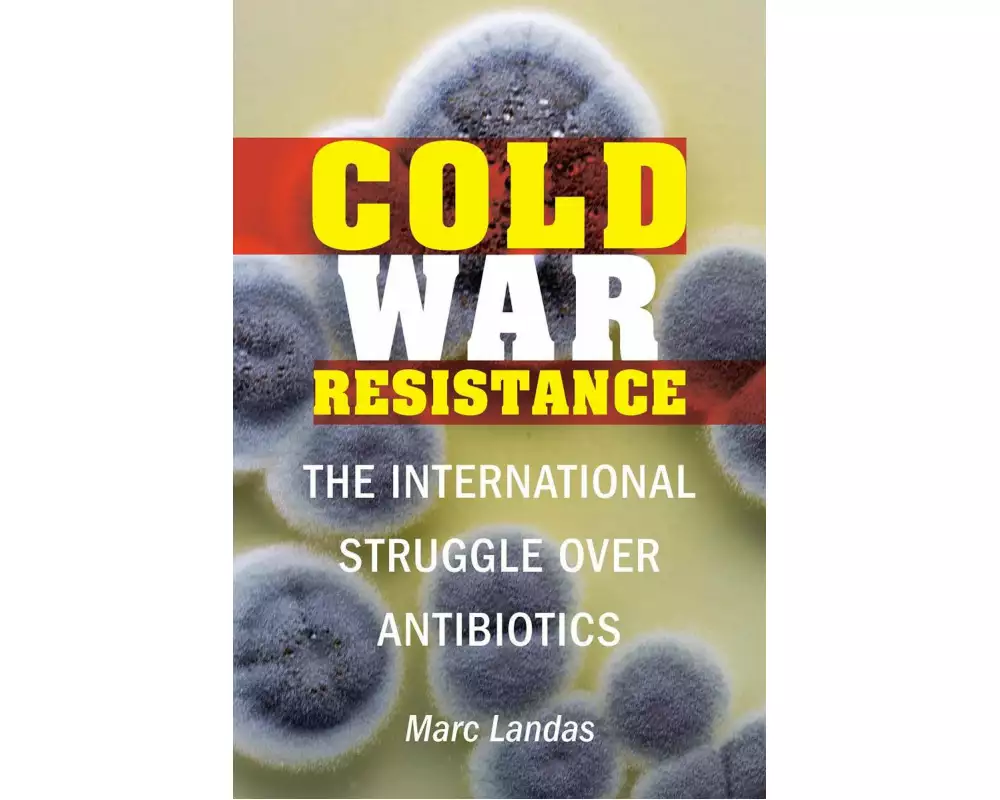
Cold War Resistance

Marke: Potomac Books
Hier finden Sie zu den besten Preisen alle Produkte der Marke Potomac Books.
Bestellungen bis 17:00 Uhr für Produkte auf Lager erhalten Sie - ohne Versandgebühr - am nächsten Werktag.
1
Meistgekauft
Auf Lager:
1
I Held Lincoln
A Union Sailor's Journey Home
CHF 38.50
2
Meistgekauft
Auf Lager:
1
Cold War Spy Stories from Eastern Europe
-5.6 %
CHF 46.75
3
Meistgekauft
Erhältlich:
Nicht auf Lager
In Search of the Romanovs
A Family's Quest to Solve One of History's Most Brutal Crimes
CHF 51.–
4
Auf Lager:
4
Coming to a Neighborhood near You
The Repercussions of Crime and Punishment
-2.1 %
CHF 41.–
5
Auf Lager:
3
Cold War Resistance
The International Struggle Over Antibiotics
-9.2 %
CHF 54.–